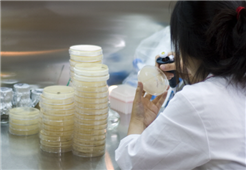
기능성식품 및 분자생물학 연구실 1
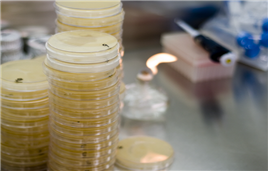
기능성식품 및 분자생물학 연구실 2

기능성식품 및 분자생물학 연구실
세부내용
- 기능성물질 생산 미생물의 분리 및 활용
- 미생물유래 효소를 이용한 기능성물질의 생산
- 재조합미생물을 이용한 고기능성 물질의 생산
- 효소단백질의 개량을 통한 효율적인 기능성물질의 생산




- 기능성물질 생산 미생물의 분리 및 활용
- 미생물유래 효소를 이용한 기능성물질의 생산
- 재조합미생물을 이용한 고기능성 물질의 생산
- 효소단백질의 개량을 통한 효율적인 기능성물질의 생산